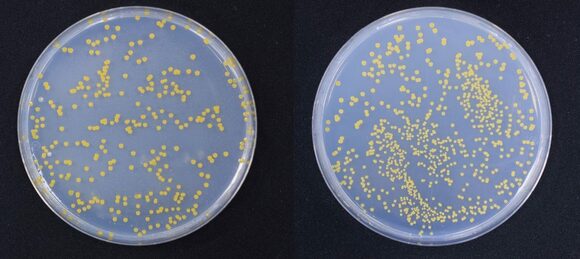
食中毒菌

つくりおきブームはは勢いが衰えず、インスタで「#作り置き」がついた投稿は64万件超。書籍も次々に出版されています。
一方で、この猛暑では、食中毒の発生リスクも心配。
そこで、食中毒を研究する衛生微生物研究センターや、つくりおきおかずについての著書が多い料理家のスガさんに、食中毒の怖さや予防法を取材しました。
おいしそうなつくりおきおかず。きちんと予防しないと見えない食中毒菌が!
キッチンで火を使いたくないような暑い日に便利な、つくりおきおかず。毎日安心して活用したいものです。
厚生労働省が発表する「食中毒統計資料」によると、気温があがる8月に向けて、食中毒件数は増加する傾向に。
しかし、20~40代の働く主婦1000人に行ったアンケートによると、9割の主婦につくりおき経験があるのに対して、食中毒対策をきちんとしている人はわずか6.7%。
半数以上は「正しい食中毒対策がわからない」と回答しています。
(「食生活に関するアンケート」2018年 ジョンソン調べ)
●見た目やにおいには変化なし!冷蔵庫保管でも菌は増える
食中毒菌は少量でも症状を引き起こす場合があり、見た目やにおいでは判別がつかないことも。
一見おいしく食べられそうな食べ物にも、菌が付着している可能性があります。
「衛生微生物研究センター」で行われた、つくりおきおかずの食中毒菌繁殖実験を見てみましょう。
菌が付着した包丁・まな板を使い、加熱調理した鶏肉を切り分け、冷蔵庫保管します。
2日目の鶏肉(左)と、7日目の鶏肉(右)。見た目はほとんど変わりません。
2日目の食中毒菌(左)、7日目には食中毒菌は1gあたり10万個増(右)。食中毒を引き起こすレベルに。
7日後には菌が食中毒を引き起こすレベルまで繁殖していたにもかかわらず、見た目やにおいには変化がありません。
いちど菌が付着すると、冷蔵保存しても菌は繁殖し続けます。そのため、きちんと調理中から菌対策をしておくことが大切になります。
食中毒予防に「手洗い」と「アルコール除菌」を見直して!
では、実際にどういう方法で食中毒菌を防ぐことができるのでしょうか。
衛生微生物研究センター監修のもと、料理家のスガさんに、普段気をつけていることを教えていただきました。
(1)手洗い
「基本中の基本ですが、もっとも有効な菌対策がこれです。調理前だけでなく、生肉に触れたあとや、トイレに行ったあとなど、調理中もこまめに行うことがポイント」
(2)アルコール除菌
「きちんと洗った調理器具も、保管している間に菌が付着してしまうことが。調理前に、使う調理器具にはアルコール除菌をしておきましょう。最近では、スプレータイプの使いやすいものがたくさん販売されています。水気があると、除菌力が弱まってしまうので、乾いた状態で使用しましょう」
(3)箸は使い回さない
「雑菌がほかのおかずに移ってしまうので、箸を使い回すのはNG。使うたびに洗うのもよいのですが、箸が乾ききっていないまま次の調理に移ると、含んだ水分が食中毒菌繁殖のもとに。料理ごとに違う箸を使うのがベスト」
(4)急冷保存
急冷保存は、つくりおき時に重宝するワザです。
「熱を入れるおかずは、粗熱を取ってから冷蔵保存をします。しかし、菌は高温多湿な環境を好むので、暑い夏に長時間料理の入った鍋を放置しておくのは危険。粗熱が取れるまで待つのではなく、シンクに冷たい水をはり、調理した鍋ごと入れてかき混ぜながら一気に冷ましましょう」
鍋底から全体が空気に触れるようにかき混ぜ、手早く冷まして冷蔵庫へ。
つくりおきおかずの食中毒を防ぎ、健康に過ごしましょう!